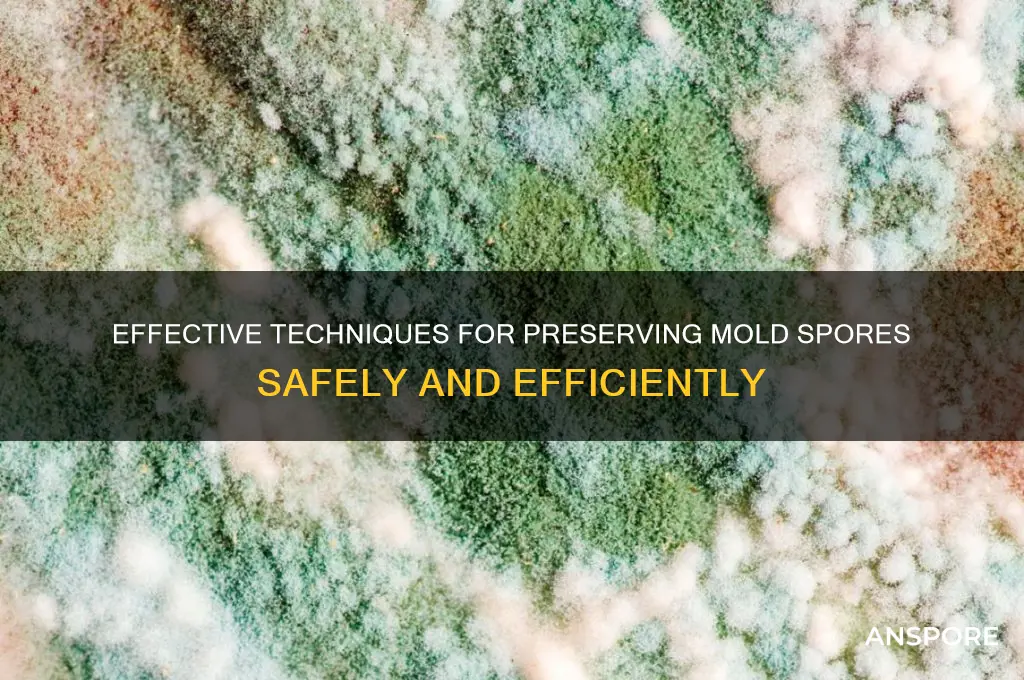
how to preserve mold spores

Preserving mold spores is a specialized process that requires careful attention to detail and adherence to specific techniques to ensure their viability and longevity. Mold spores are resilient microorganisms, but their preservation often involves creating optimal conditions that mimic their natural environment, such as controlled humidity, temperature, and substrate. Common methods include desiccation, where spores are dried and stored in airtight containers, or cryopreservation, where they are frozen at ultra-low temperatures to halt metabolic activity. Additionally, spores can be suspended in nutrient-rich media or embedded in materials like agar to maintain their integrity. Proper labeling, documentation, and storage in a stable, dark environment are essential to prevent contamination and ensure the spores remain viable for future research, identification, or cultivation purposes.
| Characteristics | Values |
|---|---|
| Storage Temperature | -20°C to -80°C (ultra-low temperature for long-term preservation) |
| Storage Medium | Sterile distilled water, glycerol (10-20%), or cryoprotective solutions |
| Container Type | Screw-cap vials, cryotubes, or ampoules made of glass or polypropylene |
| Desiccation Method | Silica gel or vacuum drying for spore suspension |
| Humidity Control | Low humidity (<10%) for desiccated spores |
| Light Exposure | Stored in dark conditions (light-proof containers or storage area) |
| Sterility | Sterile techniques and aseptic handling to prevent contamination |
| Labeling | Include species name, collection date, and storage conditions |
| Shelf Life | Up to decades when stored at -80°C; shorter for desiccated or refrigerated samples |
| Revival Method | Inoculation onto nutrient-rich agar plates or liquid media |
| Additional Preservatives | Sodium azide (0.02-0.1%) or other antimicrobial agents for short-term storage |
| pH Level | Neutral pH (7.0) for most mold spores |
| Oxygen Exposure | Anaerobic or microaerophilic conditions for specific species |
| Documentation | Detailed records of collection site, environmental conditions, and morphology |
What You'll Learn
- Optimal Storage Conditions: Maintain low humidity, cool temperatures, and darkness to prevent spore germination
- Desiccation Techniques: Use silica gel or vacuum sealing to remove moisture and preserve spores
- Chemical Preservation: Apply antifungal agents like thymol or ethanol to inhibit spore growth
- Freezing Methods: Store spores at -20°C or below to halt metabolic activity
- Agar-Based Preservation: Embed spores in agar media for long-term viability

Optimal Storage Conditions: Maintain low humidity, cool temperatures, and darkness to prevent spore germination
Mold spores, ever-present in our environment, can remain dormant for years, waiting for the right conditions to spring to life. To preserve these microscopic time capsules, understanding their Achilles' heel is crucial. Mold thrives in damp, warm, and light-filled environments. Therefore, the key to preserving spores lies in creating the opposite: a dry, cool, and dark sanctuary.
Imagine a desiccated desert landscape, devoid of moisture and scorching under a relentless sun. This is the enemy of mold spores. Aim for a relative humidity below 50% in your storage area. Silica gel packets, those ubiquitous desiccants found in packaging, are your allies here. Place them liberally within your storage container, ensuring they are renewed regularly to maintain their moisture-absorbing prowess.
Temperature plays a similarly critical role. Think of a chilly cave, its cool air preserving ancient artifacts. Mold spores, like many living things, slow their metabolic processes in cooler temperatures. Aim for a storage temperature between 4°C and 10°C (39°F and 50°F). A refrigerator, set to its warmest setting, can provide this ideal environment. Avoid freezing temperatures, as they can damage the delicate spore structures.
Darkness completes the trifecta of optimal storage conditions. Light, particularly ultraviolet (UV) radiation, can be detrimental to spore viability. Store your samples in opaque containers, shielding them from any light source. Consider using amber or brown glass vials, which offer excellent protection against UV rays.
Remember, consistency is key. Fluctuations in humidity, temperature, or light exposure can trigger spore germination. Regularly monitor your storage conditions using a hygrometer for humidity and a thermometer for temperature. By meticulously maintaining these optimal conditions, you can ensure the long-term preservation of mold spores, allowing for future study and analysis.
Concerning Levels of Stachybotrys Spores: What You Need to Know
You may want to see also

Desiccation Techniques: Use silica gel or vacuum sealing to remove moisture and preserve spores
Mold spores, resilient as they are, thrive in moisture-rich environments. To preserve them effectively, desiccation techniques emerge as a powerful solution. By removing moisture, these methods halt metabolic activity and prevent degradation, ensuring long-term viability. Silica gel and vacuum sealing stand out as two primary tools in this approach, each offering unique advantages and considerations.
Silica gel, a granular, porous material, acts as a moisture scavenger. Its high surface area and affinity for water make it ideal for desiccating mold spores. To use silica gel effectively, place a sufficient quantity (typically 10-20 grams per liter of storage volume) in a sealed container alongside the spore sample. Ensure the silica gel is dry and orange indicating beads are present to monitor moisture absorption. Over time, the beads will turn green as they saturate, signaling the need for replacement. This method is cost-effective and accessible, making it a popular choice for both amateur and professional preservationists.
Vacuum sealing, on the other hand, removes moisture by creating a low-pressure environment. This technique involves placing the spore sample in a vacuum-sealed bag or container, effectively eliminating air and, consequently, humidity. For optimal results, combine vacuum sealing with a desiccant like silica gel to ensure any residual moisture is absorbed. Vacuum sealing is particularly useful for preserving large quantities of spores or for long-term storage, as it minimizes exposure to oxygen and contaminants. However, it requires specialized equipment, which may be a limiting factor for some users.
Comparing the two methods, silica gel offers simplicity and affordability, while vacuum sealing provides a more comprehensive moisture removal solution. For short-term preservation or small-scale projects, silica gel alone may suffice. In contrast, vacuum sealing, especially when paired with silica gel, is ideal for long-term or large-scale preservation needs. Regardless of the chosen method, monitoring storage conditions and periodically inspecting the spores for signs of degradation are essential practices.
In conclusion, desiccation techniques using silica gel or vacuum sealing provide effective means to preserve mold spores by eliminating moisture. Each method has its strengths, and the choice depends on the specific requirements of the preservation project. By understanding and applying these techniques, individuals can ensure the longevity and viability of their mold spore collections, whether for research, education, or practical applications.
Effective Strategies to Eradicate Bacterial Spores in Medical Environments
You may want to see also

Chemical Preservation: Apply antifungal agents like thymol or ethanol to inhibit spore growth
Chemical preservation offers a targeted approach to inhibiting mold spore growth, leveraging the power of antifungal agents like thymol and ethanol. These compounds disrupt cellular processes essential for spore germination and proliferation, effectively halting mold development in its tracks. Thymol, a natural monoterpene phenol derived from thyme oil, acts by damaging fungal cell membranes and inhibiting enzyme function. Ethanol, a widely used alcohol, denatures proteins and disrupts lipid bilayers, rendering spores incapable of metabolic activity. Both agents are particularly effective in preserving organic materials such as paper, textiles, and wood, where mold poses a significant threat.
Applying these antifungal agents requires precision to ensure efficacy without damaging the material being preserved. For thymol, a common method involves dissolving it in a solvent like acetone or ethanol to create a 1–2% solution, which is then applied via spraying or brushing. Ethanol is typically used undiluted or in concentrations of 70–90% for optimal antifungal activity. When treating porous materials, such as paper or fabric, immersion in the solution for 10–15 minutes ensures thorough penetration. Non-porous surfaces, like glass or metal, can be wiped down with a saturated cloth. It’s crucial to allow treated items to dry completely in a well-ventilated area to prevent moisture-related issues.
While chemical preservation is effective, it’s not without limitations. Thymol’s strong odor may linger, making it less suitable for items intended for immediate use or display. Ethanol’s flammability requires careful handling, particularly in large-scale applications. Additionally, repeated treatments may be necessary for long-term preservation, as the agents can degrade over time. For archival materials, testing a small, inconspicuous area first is essential to avoid discoloration or structural damage. Despite these cautions, when used correctly, thymol and ethanol provide a reliable barrier against mold, extending the lifespan of vulnerable artifacts.
Comparatively, chemical preservation stands out for its immediacy and potency. Unlike environmental controls, which rely on humidity and temperature regulation, antifungal agents act directly on spores, offering rapid protection. However, it’s most effective when combined with preventive measures, such as proper storage and regular inspections. For institutions like museums or archives, integrating chemical preservation into a broader conservation strategy ensures comprehensive mold prevention. By understanding the strengths and limitations of thymol and ethanol, practitioners can make informed decisions to safeguard valuable materials from fungal degradation.
Understanding Morel Spores: Lifespan, Viability, and Storage Tips
You may want to see also

Freezing Methods: Store spores at -20°C or below to halt metabolic activity
Freezing mold spores at -20°C or below is a proven method to suspend their metabolic activity, effectively preserving them for extended periods. This technique leverages the principle that low temperatures slow biochemical reactions, rendering spores dormant without causing irreversible damage. Unlike desiccation or chemical preservation, freezing offers a straightforward, cost-effective solution that maintains spore viability for future research, agriculture, or industrial applications. However, success hinges on precise execution to prevent ice crystal formation, which can rupture cell walls and compromise integrity.
To implement this method, begin by suspending the spores in a cryoprotectant solution, such as 10% glycerol or skim milk, to minimize cellular damage during freezing. Glycerol, in particular, penetrates cell membranes and reduces ice crystal formation, while skim milk provides nutrients and stabilizes spore structure. After suspension, aliquot the mixture into sterile vials, leaving minimal headspace to prevent evaporation. Label each vial with the spore type, concentration, and date, ensuring traceability. Gradually cool the samples to -20°C using a controlled-rate freezer or by storing them in a -20°C freezer directly, avoiding rapid temperature changes that could shock the spores.
While freezing is effective, it’s not without risks. Temperature fluctuations or improper thawing can reduce spore viability. For long-term storage, consider transferring samples to -80°C after initial freezing, as this further stabilizes spores for decades. When thawing, do so rapidly in a 25–37°C water bath to prevent prolonged exposure to damaging temperatures. Never refreeze spores after thawing, as this can significantly decrease their survival rate. Regularly assess viability using standard plating techniques to ensure preservation success.
Comparatively, freezing stands out as a balance between simplicity and efficacy. While lyophilization (freeze-drying) offers longer shelf life, it requires specialized equipment and can be costly. Chemical preservation methods, such as using formaldehyde, may alter spore properties, limiting their utility in certain applications. Freezing at -20°C or below, however, retains spore functionality with minimal investment, making it ideal for laboratories or institutions with limited resources. Its reliability and accessibility underscore its position as a cornerstone technique in spore preservation.
Using Weed Killer with Milky Spore Granules: Safe or Risky?
You may want to see also

Agar-Based Preservation: Embed spores in agar media for long-term viability
Mold spores, when embedded in agar media, can retain viability for years, making agar-based preservation a cornerstone technique in microbiology. This method leverages the stability and nutrient-rich environment of agar to protect spores from desiccation, UV radiation, and other environmental stressors. By encapsulating spores within a semi-solid matrix, agar ensures they remain dormant yet viable until reactivation is required. This approach is particularly valuable for preserving rare or genetically unique mold strains, ensuring their availability for future research, industrial applications, or ecological studies.
To implement agar-based preservation, begin by preparing a nutrient-rich agar medium, such as potato dextrose agar (PDA) or malt extract agar (MEA), commonly used for mold cultivation. Autoclave the agar to sterilize it, then allow it to cool to approximately 50°C to prevent spore damage during inoculation. Suspend the mold spores in a sterile solution, such as distilled water or a buffer, and mix them gently into the liquefied agar. Pour the spore-agar mixture into sterile tubes or plates, ensuring an even distribution. Slant the tubes at a 45-degree angle for optimal surface area and storage efficiency. Once solidified, seal the tubes with cotton plugs or caps to prevent contamination while allowing gas exchange.
The success of agar-based preservation hinges on storage conditions. Maintain the embedded spores at 4°C for short-term storage (up to 6 months) or -20°C for long-term preservation (several years). Avoid repeated freeze-thaw cycles, as these can compromise spore viability. Periodically check stored cultures for contamination by subculturing onto fresh agar plates. If contamination occurs, discard the sample and restart the preservation process with a clean isolate. Label tubes with strain details, preservation date, and storage conditions for traceability.
Compared to other preservation methods, such as freeze-drying or cryopreservation, agar-based preservation is cost-effective and requires minimal specialized equipment. However, it is less suitable for large-scale storage due to the bulkiness of agar tubes. For researchers or institutions with limited resources, this method offers a practical balance between viability maintenance and logistical simplicity. Its reliability has made it a standard in laboratories worldwide, ensuring mold spores remain accessible for diverse applications, from antibiotic discovery to food spoilage studies.
Unlocking Urban Growth: Strategies to Engage Cities via Social Spore
You may want to see also
Frequently asked questions
Mold spores are best preserved in cool, dry, and dark environments. Store them in airtight containers at temperatures between 4°C (39°F) and 25°C (77°F) to prevent degradation and maintain viability.
Yes, mold spores can be preserved in liquid solutions like glycerol or water with added preservatives. Glycerol is commonly used as it prevents freezing damage and maintains spore integrity when stored at -20°C (-4°F).
When stored under optimal conditions (cool, dry, and dark), mold spores can remain viable for several years to decades. However, viability decreases over time, so periodic testing is recommended for long-term preservation.

